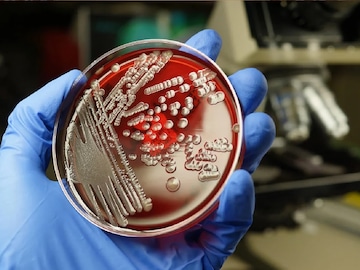

২০৫০ সাল নিয়ে ভয়ঙ্কর ভবিষ্যদ্বাণী! মানুষের নিজের দোষেই আসছে বড় 'বিপদ'
- Published by:Suman Majumder
- news18 bangla
Last Updated:
Antimicrobial Resistance: অ্যান্টিবায়োটিকের সেবনের ফলে মানুষের সামনে এখন বড় বিপদ। মুড়ি-মুড়কির মতো সেই ওষুধ খেয়েই সমস্যা বেড়েছে। চিকিৎসকরা দীর্ঘদিন ধরে অ্যান্টিবায়োটিক খাওয়ার ব্যাপারে সতর্ক করেন। এবার একশ্রেণির জীবাণুর বাড়বাড়ন্ত।
কলকাতা: বিশ্বে সব সময় নানা রোগের আশঙ্কা থাকে। তবে এবার ‘অ্যান্টিমাইক্রোবিয়াল রেজিস্ট্যান্স’ নতুন করে ভয়ের পরিবেশ তৈরি করছে।
জাতিসংঘের সাধারণ পরিষদ এই রোগের উপর দ্বিতীয় উচ্চ-স্তরের বৈঠক করার প্রস্তুতি নিচ্ছে। কারণ একটি নতুন গবেষণায় দেখা দিয়েছে, মানুষ নিজের দোষেই বড় বিপদের জন্ম দিয়েছে।
অ্যান্টিবায়োটিকের সেবনের ফলে মানুষের সামনে এখন বড় বিপদ। মুড়ি-মুড়কির মতো সেই ওষুধ খেয়েই সমস্যা বেড়েছে। চিকিৎসকরা দীর্ঘদিন ধরে অ্যান্টিবায়োটিক খাওয়ার ব্যাপারে সতর্ক করেন। এবার একশ্রেণির জীবাণুর বাড়বাড়ন্ত।
advertisement
advertisement
আরও পড়ুন- সোয়া ২টোয় বড় ঘটনা! সত্যিই ১৫ সেপ্টেম্বর পৃথিবী ধংস হত! কান ঘেঁষে গেল ‘বিপদ’
অ্যান্টিবায়োটিক প্রতিরোধী সংক্রমণ হতে পারে বলে আশঙ্কা করা হচ্ছে। গবেষকরা দাবি করেছেন, ২০৫০ সালের মধ্যে ৪ কোটি মানুষের মৃত্যু হবে অ্যান্টিবায়োটিক প্রতিরোধী সংক্রমণের কারণে। অ্যান্টিমাইক্রোবিয়াল রেজিস্ট্যান্স (AMR) সংক্রমণ বড় আশঙ্কার কারণ হয়ে দেখা দিয়েছে।
advertisement
গ্লোবাল রিসার্চ অন অ্যান্টিমাইক্রোবিয়াল রেজিস্ট্যান্স (GRAM) এই ভবিষ্যদ্বাণী করেছে। ‘দ্য ল্যানসেট’-এ প্রকাশিত এই সমীক্ষার রিপোর্ট নিয়ে রাষ্ট্রসংঘ উদ্বেগ প্রকাশ করেছে।
ভারত, পাকিস্তান ও বাংলাদেশের মতো দক্ষিণ এশিয়ার দেশগুলো এই রোগে ব্যাপকভাবে আক্রান্ত হবে বলে আশঙ্কা করা হচ্ছে। অস্ট্রেলিয়ার আরএমআইটি ইউনিভার্সিটির ইমিউনোলজি এবং অন্ত্রের স্বাস্থ্যের অধ্যাপক রাজারমন এরি বলেছেন, “অণুজীবগুলি আর ওষুধে কার্যকরভাবে সাড়া না দেওয়ায় ব্যাকটেরিয়া, ভাইরাস, ছত্রাক এবং ভাইরাসের অ্যান্টিমাইক্রোবিয়াল রেজিস্ট্যান্স দেখা দেয়, এই সংক্রমণের চিকিত্সা করা কঠিন।”
advertisement
আরও পড়ুন- General Knowledge: কোন প্রাণী জন্মের পর টানা ২ মাস ঘুমায়? উত্তর দিতে ব্যর্থ
সমস্ত বয়সের মানুষের মধ্যে ১১টি সংক্রামক সিন্ড্রোমের প্রভাব পড়তে পারে। গবেষকরা এখন থেকেই অনুমান করেছেন, ২০৫০ সাল নাগাদ AMR- এর কারণে বার্ষিক মৃত্যু ১.৯১ মিলিয়ন বৃদ্ধি পেতে পারে।
Location :
Kolkata,Kolkata,West Bengal
First Published :
Sep 19, 2024 3:16 PM IST